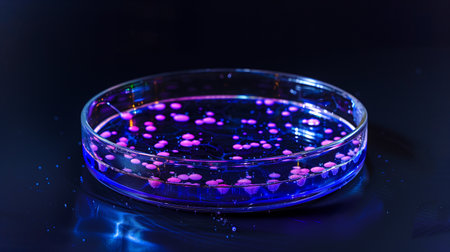
Colorful stem cells in a petri dish demonstrate their unique regenerative propertiesの素材

素材 - Colorful stem cells in a petri dish demonstrate their unique regenerative properties
作品情報
Colorful stem cells in a petri dish demonstrate their unique regenerative properties
- ID:248525616
- 作品種別:
- 作者名:milkos
キーワード
- advancements
- ai
- analysis
- applications
- biology
- biotechnology
- cell
- cellular
- culture
- development
- dish
- environment
- evaluation
- experiment
- experimentation
- expertise
- fluid
- generated
- growth
- healing
- health
- imaging
- innovation
- laboratory
- medical
- medicine
- methodologies
- microscopic
- observation
- organism
- outcomes
- petri
- pink
- pluripotent
- properties
- regenerative
- regulation
- renewal
- research
- science
- stem
- study
- technique
- technologies
- therapy
- tissue
- treatment
- violet
類似作品
3d illustration...
Vivid colors de...
Abstract biolog...
colorful staine...
A close up of a...
Vivid soap foam...
Colorful microo...
Colorful abstra...
Colorful variet...
This image appe...
Cells and struc...
cross-section o...
Colorful abstra...
Vivid Connectiv...
Microscopic Org...
Bacterial colon...
Abstract liquid...
Abstract colorf...
Microscopic Vie...
Colored molecul...
Colorful repres...
abstract fluid ...
This striking i...
A vibrant close...
An intriguing s...
Close-up detail...
Microscopic Org...
Abstract illust...
3d illustration...
Macro close up ...
Ricordea mushro...
Microscopic vie...
Oil and tenside...
Web Abstract Cr...
3d abstract com...
Intricate micro...
Abstract bright...
Macro shot of c...
Bacteria under ...
Abstract Plant ...
A detailed 3D e...
Glass test tube...
abstract biolog...
abstract biolog...
Vibrant swirls ...
Rather crazy, r...
Abstract object...